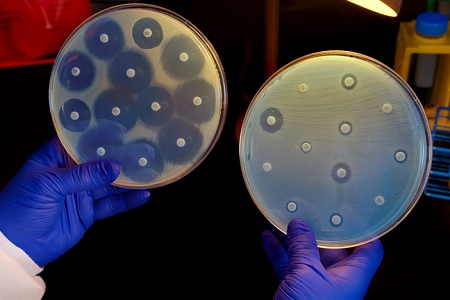
batteri antibiotico

Scoperto il nuovo antibiotico contro i "superbatteri"
È degli ultimi giorni la clamorosa notizia che arriva dalla Northeastern University di Boston, dove il team di ricercatori guidati da Kim Lewis è riuscita a scoprire un nuovo antibiotico in grado di neutralizzare alcuni tra i batteri più resistenti in natura.
Parliamo soprattutto del famigerato Mycobacterium tuberculosis, responsabile della Tubercolosi, ma anche del Clostridium difficile e dello Staphylococcus aureus.
Tutti questi batteri hanno in comune non solo la pericolosità per il nostro organismo e per quello dei nostri animali, ma anche il fatto che nel corso degli anni sono diventati sempre meno sensibili nei confronti della maggior parte degli antibiotici conosciuti.
Questo meccanismo prende il nome di “antibiotico-resistenza” e si sviluppa ogni volta che un batterio riesce a “nascondersi” da un antibiotico.
Questo meccanismo prende il nome di “antibiotico-resistenza” e si sviluppa ogni volta che un batterio riesce a “nascondersi” da un antibiotico.
Cerchiamo di capire meglio questo concetto.
I batteri sono rivestiti da una struttura esterna, formata da diverse componenti, tra cui piccole proteine e grassi.
La maggior parte degli antibiotici agisce proprio sulle proteine che compongono il rivestimento esterno dei batteri, che in questo modo perdono la propria copertura protettiva e tendono a morire.
Man mano che vengono somministrati ripetutamente gli antibiotici, i batteri, il cui obiettivo principale è quello di sopravvivere e riprodursi, cercano di studiare un modo per poter neutralizzare l’azione degli antibiotici.
È proprio così, quindi, che eliminano le proteine che compongono il loro rivestimento esterno, per sostituirle con altre proteine diverse, che quindi non possono essere riconosciute e danneggiate dagli antibiotici.
L’innovativa scoperta di Kim Lewis influisce proprio su questo meccanismo. Il nuovo antibiotico, infatti, che prende il nome di teixobactin, è in grado di agire non più sulle proteine che formano la struttura esterna dei batteri, ma sui grassi, che sono più difficili da sostituire.
Tutto ciò contribuisce senza dubbio a ridurre drasticamente il rischio che i batteri possano sviluppare nuovamente il meccanismo della resistenza agli antibiotici.
Inoltre, un altro fattore importante è che finora alcune infezioni non potevano essere curate definitivamente, proprio perché mancavano gli antibiotici specifici per i batteri responsabili.
Grazie alla nuova scoperta, invece, è stato possibile creare un farmaco specifico e mirato, soprattutto perché è stato messo a punto un innovativo sistema per cercare e studiare i batteri.
In laboratorio, infatti, i batteri norm almente vengono prelevati dall’aria, dal corpo o da altre superfici, e vengono messi in degli appositi contenitori, insieme a delle sostanze che possano nutrirli e garantirne la crescita e la riproduzione.
almente vengono prelevati dall’aria, dal corpo o da altre superfici, e vengono messi in degli appositi contenitori, insieme a delle sostanze che possano nutrirli e garantirne la crescita e la riproduzione.
È solo in questo modo che gli studiosi possono analizzarne la struttura, per mettere a punto dei farmaci specifici.
Purtroppo, alcuni di questi batteri più pericolosi si trovano solo nel suolo, insieme ad un’infinità di microrganismi diversi. Per questo motivo è molto difficile riuscire ad isolarne un solo tipo, per prelevarlo ed analizzarlo.
Lo studio della Northeastern University di Boston, invece, è riuscito ad ideare un innovativo sistema per la raccolta dei batteri. Sono state utilizzati, infatti, degli appositi strumenti per consentire l’isolamento e la crescita dei batteri direttamente nel terreno.
Solo così è stato possibile in seguito analizzarli nel modo più adatto, cogliendone i punti deboli sui quali il nuovo antibiotico avrebbe dovuto agire in maniera mirata.
Il nuovo farmaco dovrà ora essere testato in modo più approfondito, per cui trascorrerà ancora qualche anno prima di poterne usufruire in medicina umana e veterinaria.
In ogni caso, si ritiene che grazie a questi studi molto presto avremo a disposizione molecole ancora più innovative per curare molte altre malattie infettive.
